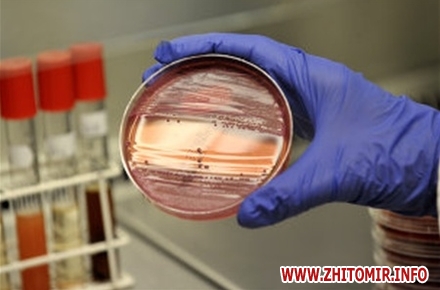

У Бердичеві після вживання сиру, купленого в місцях стихійної торгівлі, на кишкову інфекцію захворіла сім’я: батько, мати і 3 дітей віком 9 років та близнюки віком 2,5 років.
Про це Житомир.info повідомила перс-служба Державної установи «Житомирський обласний лабораторний центр Держсанепідслужби України».
«В місті Бердичеві, після вживання сиру кисломолочного домашнього приготування, захворіла вся сім’я – батько, мати і 3 дітей - віком 9 років та близнюки віком 2,5 років. Домашній сир був придбаний у приватної особи в місці стихійної торгівлі по вул.Житомирській в районі м’ясокомбінату. Продукт негарантованої якості виготовлявся та реалізовувався з порушенням санітарних правил», – йдеться в повідомленні.
Протягом останніх місяців значно зросла захворюваність населення області гострими кишковими інфекціями, пов’язаними з вживанням харчових продуктів, придбаних на стихійних ринках.
«Також значно зросла і кількість стихійних ринків, де продаються харчові продукти з порушенням санітарних норм: з землі, без холоду, в антисанітарних умовах. Так, наприклад, в м.Житомирі харчові продукти продаються на стихійних ринках по вул.Небесної Сотні, Довженка, Лятошинського, по проспекту Миру, в районах сінного ринку, залізничного вокзалу та в інших невстановлених місцях», – повідомила прес-служба.
Як повідомляв Житомир.info, у Житомирській області маленька дитина отруїлась печенею з лісовими грибами.
























